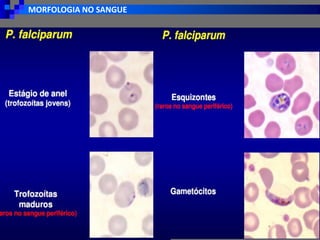
MORFOLOGIA NO SANGUE
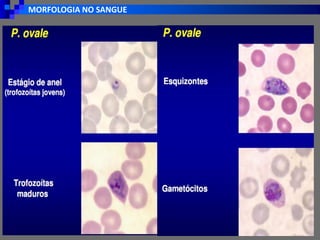
MORFOLOGIA NO SANGUE

A malária, causada por protozoários do gênero Plasmodium, afeta quase metade da população mundial, levando a 244 milhões de casos e 619.000 mortes em 2021, principalmente entre crianças menores de 5 anos. No Brasil, a transmissão ocorre por mosquitos fêmeas do gênero Anopheles, e a doença apresenta sintomas que variam de acordo com o acesso malárico, podendo resultar em condições graves. O diagnóstico é frequentemente realizado por microscopia e, quando necessário, confirmado por métodos mais avançados como a PCR.